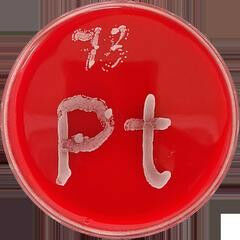
A Petri dish with red agar on which grows a fungal strand in the shape of the el

A Petri dish with red agar on which grows a fungal strand in the shape of the element symbol for platinum (Pt).
A Petri dish with red agar on which grows a fungal strand in the shape of the element symbol for platinum (Pt).
A Petri dish with red agar on which grows a fungal strand in the shape of the element symbol for platinum (Pt). CO-ADD - An international collaboration led by researchers from the University of Bern and the University of Queensland in Australia has demonstrated that chemical compounds containing special metals are highly effective in fighting dangerous fungal infections. These results could be used to develop innovative drugs which are effective against resistant bacteria and fungi. Each year, more than one billion people contract a fungal infection. Although they are harmless to most people, over 1.5 million patients die each year as a result of infections of this kind. While more and more fungal strains are being detected that are resistant to one or more of the available drugs, the development of new drugs has come to a virtual standstill in recent years. Today, only around a dozen clinical trials are underway with new active agents for the treatment of fungal infections.
TO READ THIS ARTICLE, CREATE YOUR ACCOUNT
And extend your reading, free of charge and with no commitment.
Your Benefits
- Access to all content
- Receive newsmails for news and jobs
- Post ads